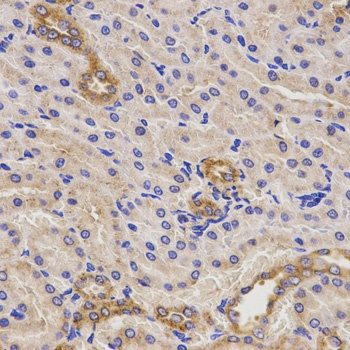
TNFRSF1B Antibody

You have no items in your shopping cart.
TNFRSF1B Antibody
Catalog Number: orb1260359
| Catalog Number | orb1260359 |
|---|---|
| Category | Antibodies |
| Description | TNFRSF1B Antibody |
| Target | TNFRSF1B |
| Clonality | Polyclonal |
| Isotype | IgG |
| Conjugation | Unconjugated |
| Reactivity | Human, Mouse, Rat |
| Form/Appearance | Liquid |
| Concentration | batch dependent |
| Buffer/Preservatives | Liquid |
| Purification | Affinity purification |
| Immunogen | Recombinant fusion protein containing a sequence corresponding to amino acids 30-250 of human TNFRSF1B (NP_001057.1). |
| UniProt ID | P20333 |
| MW | Observed: 60kDa |
| Tested applications | IHC, WB |
| Application notes | WB: 1:500 - 1:2000IHC: 1:50 - 1:200 |
| Antibody Type | Primary Antibody |
| Storage | Maintain refrigerated at 2-8°C for up to 2 weeks. For long term storage store at -20°C in small aliquots to prevent freeze-thaw cycles. |
| Alternative names | p75, TBPII, TNFBR, TNFR2, CD120b, TNFR1B, TNFR80, Read more... |
| Research Area | Cancer Biology, Cell Biology, Immunology & Inflamm Read more... |
| Note | For research use only |

Western blot analysis of extracts of mouse liver, using TNFRSF1B antibody (orb1260359) at 1:1000 dilution. Secondary antibody: HRP Goat Anti-Rabbit IgG (H+L) at 1:10000 dilution. Lysates/proteins: 25 ug per lane. Blocking buffer: 3% nonfat dry milk in TBST.
Immunohistochemistry of paraffin-embedded rat kidney using TNFRSF1B antibody (orb1260359) at dilution of 1:200 (40x lens).

Immunohistochemistry of paraffin-embedded human lung cancer using TNFRSF1B antibody (orb1260359) at dilution of 1:200 (40x lens).

Immunohistochemistry of paraffin-embedded human rectal cancer using TNFRSF1B antibody (orb1260359) at dilution of 1:200 (40x lens).
TNFR2 Recombinant Rabbit Monoclonal Antibody [orb612211]
IF, IHC-Fr, IHC-P
Mouse, Rat
Human
Rabbit
Recombinant
Unconjugated
50 μl, 100 μlRat Tumor Necrosis Factor Receptor Superfamily, Member 1B (TNFRSF1B) ELISA Kit [orb780473]
Rat
0.16-10 ng/mL
0.056 ng/mL
48 T, 96 THuman Tumor Necrosis Factor Receptor Superfamily, Member 1B (TNFRSF1B) ELISA Kit [orb775211]
Human
0.16-10 ng/mL
0.061 ng/mL
48 T, 96 TTNF-R2 rabbit pAb [orb766497]
ELISA, IF, IHC-P, WB
Human, Mouse, Rat
Polyclonal
Unconjugated
50 μl, 100 μlTNFRSF1B Antibody [orb632013]
ELISA, FC, IF, IHC, IP, WB
Human, Mouse, Rat
Rabbit
Polyclonal
Unconjugated
100 μg, 50 μg
TNFRSF1B Antibody (orb1260359)
Participating in our Biorbyt product reviews program enables you to support fellow scientists by sharing your firsthand experience with our products.
Login to Submit a Review




















